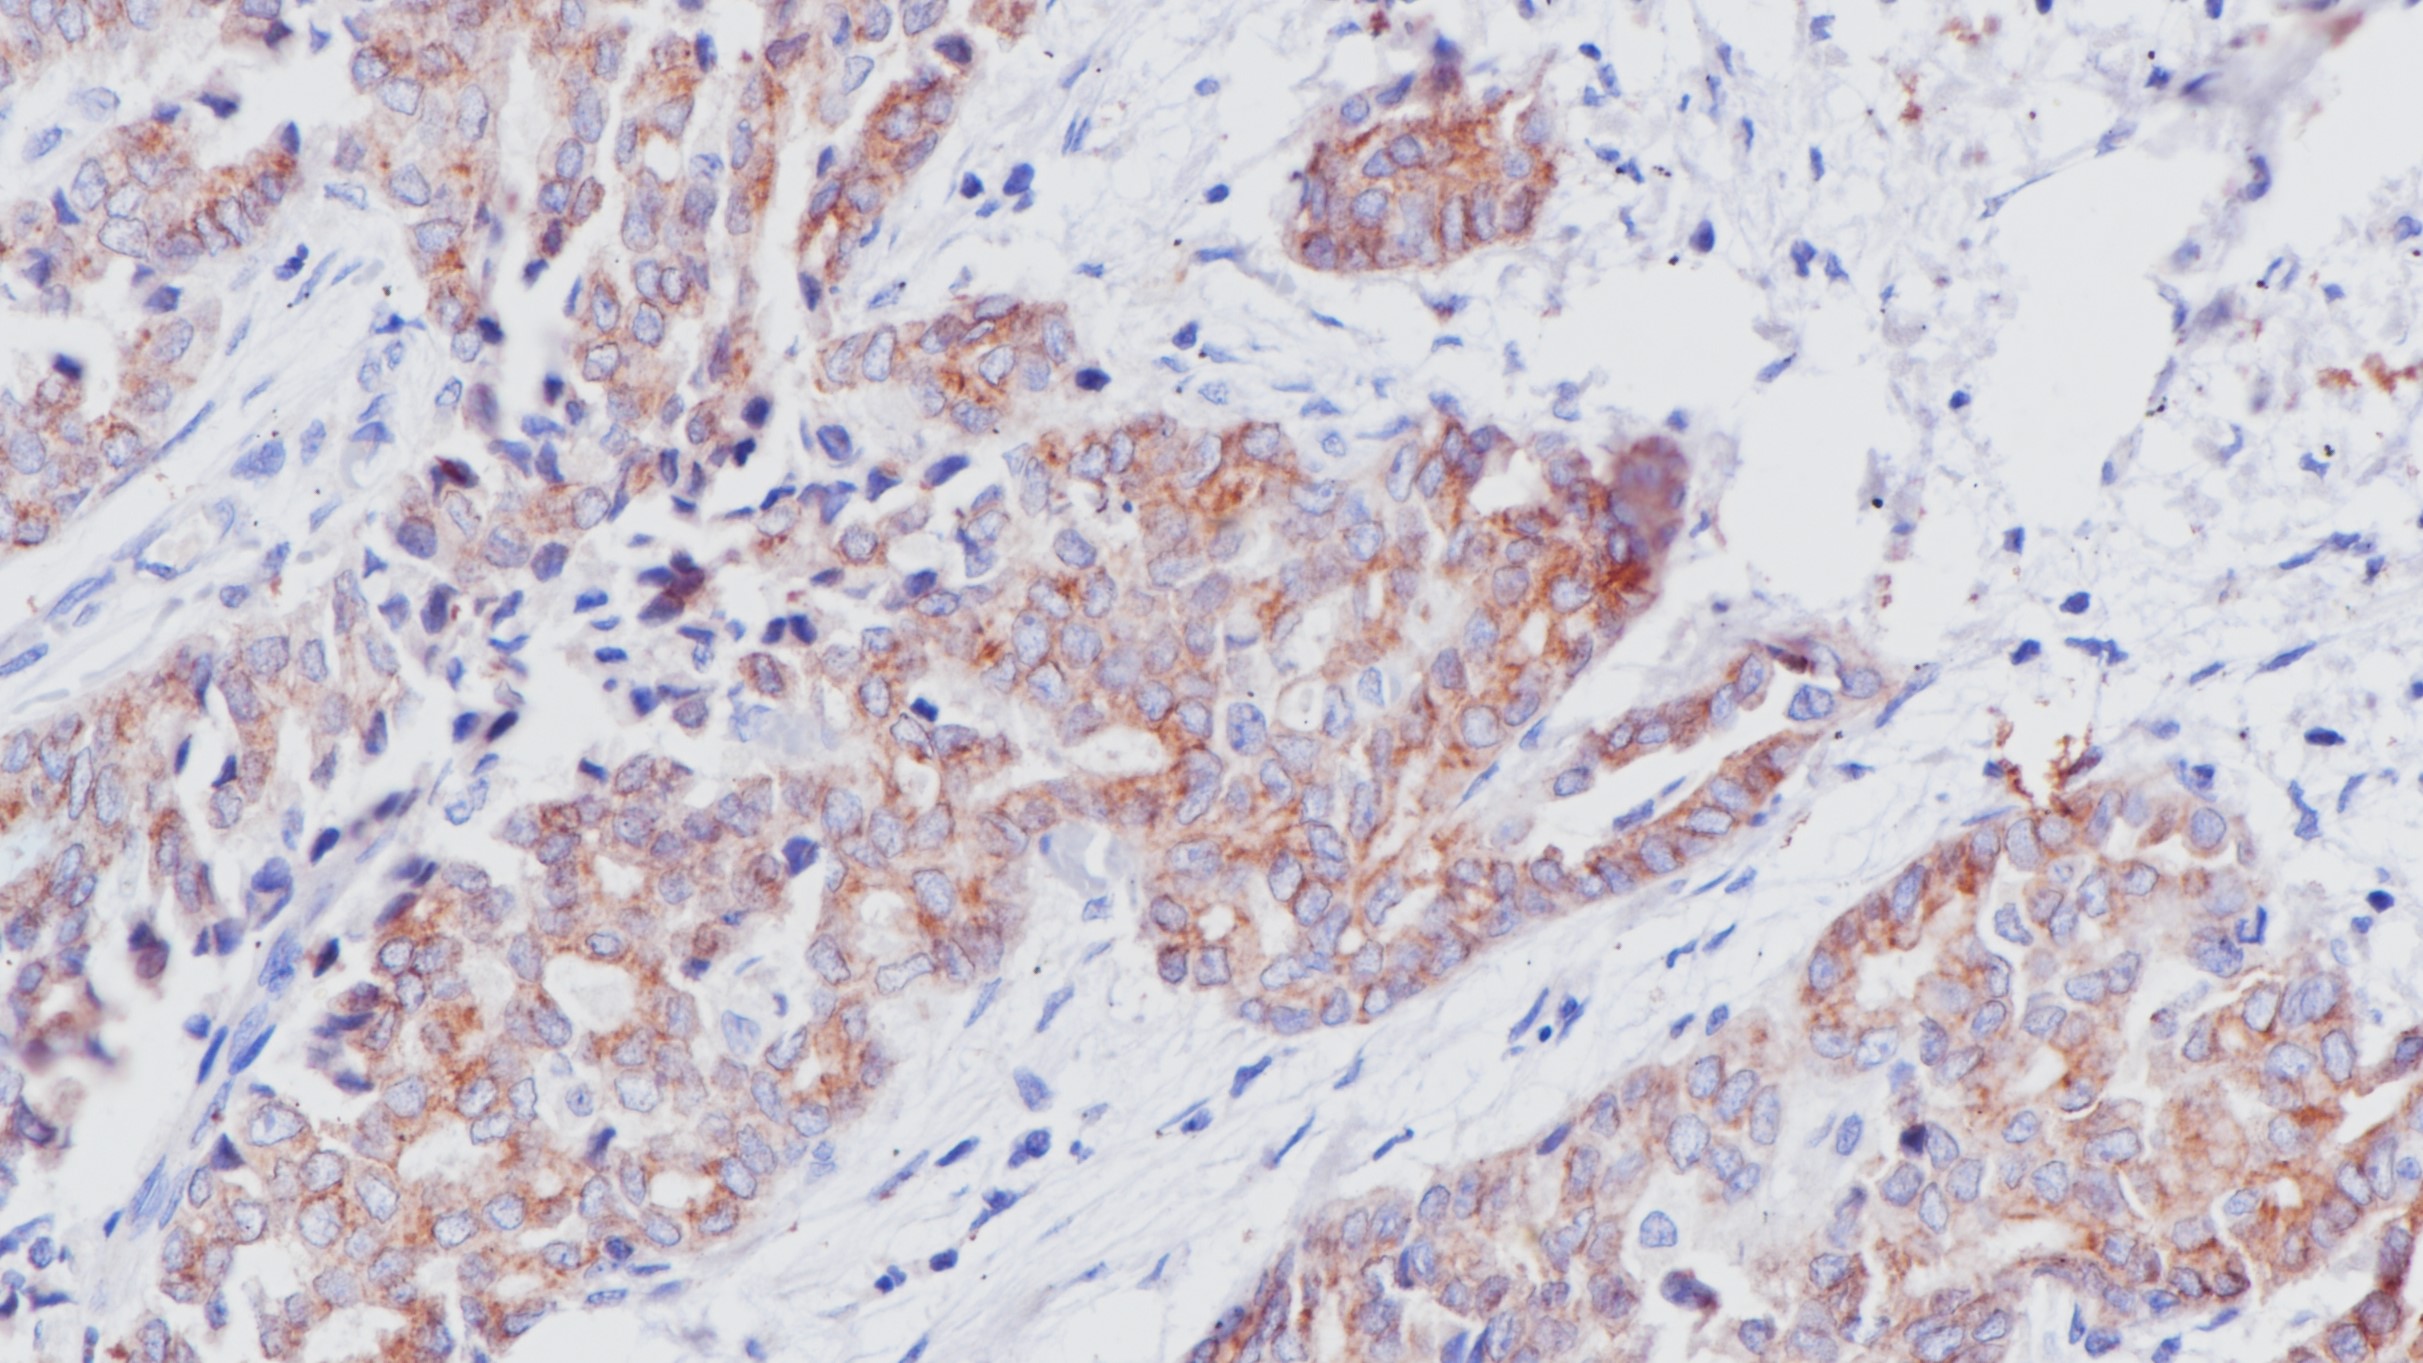
非小细胞肺癌ALK(BP6165)染色

1.Real world experience of treatment and outcome in ALK-rearranged metastatic nonsmall cell lung cancer: A multicenter study from India[J]. Amol Patel,Ullas Batra,Kuruswamy Thurai Prasad,Deepak Dabkara,Joydeep Ghosh,Manasi Sharma,Navneet Singh,P. Suresh,Parveen Jain,Prabhat Singh Malik,Priyanshu Choudhary,Sandip Ganguly,Sachin Khurana,Shivashankara MS,Sneha Bothra,Valliappan Muthu,Bivas Biswas. Current Problems in Cancer.
2.Identifying Mechanisms of Resistance to ALK Tyrosine Kinase Inhibitors Using Analysis of Circulating Tumor DNA[J]. Benjamin Solomon. Journal of Thoracic Oncology. 2020(4)
3.中华医学会.《临床技术操作规范·病理学分册》.人民军医出版社,2004.